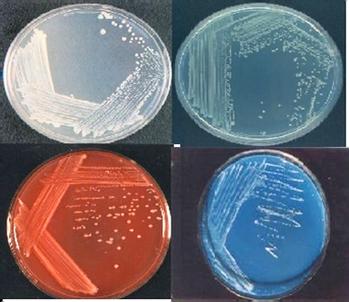
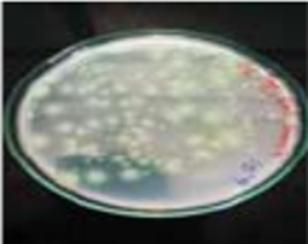

With warm regards, Nihar Ranjan, IFS
Chief Conservator of Forests (Research)
MESSAGE FROM DEPUTY CONSERVATOR OF FORESTS
With kind regards, Dr. K. Arivoli, Deputy Conservator of Forests, SFRI
In teak plantations, research has been done on integrating Gliricidia sepium and Sesbania sesban, which greatly improves soil fertility and encourages plant growth. According to preliminary findings, Sesbania sesban enriches the soil by assisting in the fixation of nitrogen, whilst Gliricidia sesban builds organic matter and strengthens the structure of the soil. When combined, these species significantly increase the production and general health of the soil in teak plantations.





Under the Green Tamilnadu Mission,the Forest Genetics Division has raised teak stumps in seven research centres. Physical purity-tested Seeds from the standard seed source have been utilized for raising stumps. Seeds are treated as per the pre-sowing treatment for ten days (Alternate wetting and drying). More than 80 percent of germination has been noticed and documented in all the centres. Raised stumps will be handed over to divisions as per the instruction of PCCF, GTM.

Ancient Tamil Literature
Gmelina arborea (�மி�) seeds are treated and dispersed by ruminants through chewing and spitting.
**Agroforestry Research Range, Erode has initiated Melia dubia nursery with Spotted deer-eaten Fruit seeds and found better results. Experiments will be carried out in this Range.







Forest Genetics Division supplied seeds to the NCC students of MGM College and assisted in preparing seed balls in July 2024. The seed balls were thrown in the Ayiramkal Reserve Forest area, Pollachi, as part of eco club activities. Forest Genetics Division Field Staffare monitoring and documenting the seed ball's growth.
Dr. R. Rajmohan DCF, FG, CBE
Forest Genetics Division has prepared Seed tree using 22 different Tree species seeds to create public awareness for Green Tamil Nadu. The tree seed display was kept at the Bookfair Event, Codissa, Coimbatore on 19, July 2024. Seed availability and the importance of trees have been explained to the visitors, and pamphlets have been distributed.









Under the JA research Scheme, the Forest Genetic Division has successfully established Palmatum with ten different native palm species in the Varatupallam Research Centre, Erode. Palmatam showcases the ecological importance of Palm, the State Tree of Tamilnadu. This facility will serve as an educational resource, highlighting the diverse applications of palms in various industries, including horticulture, medicine, and sustainable architecture.



















After 20 years of establishment, the Anthiyur clonal teak shows 82 surviving trees with an average height of 932.6 cm and an average girth of 39.4 cm. In comparison, the local teak has only 8 surviving trees but exhibits better growth, with an average height of 1165 cm and an average girth of 50.6 cm. Both types have shown regular flowering and fruiting. Although the overall growth performance is similar, the local teak outperforms the Anthiyur clonal teak in height and girth. The experiment plot will be maintained and conserved for future seed sourcing and vegetative propagation.
Thiru T. Kannan DCF, MND
“Between
The project focuses on the inventory and selection of superior genetic resources of Albizia odoratissima for establishing a field gene bank. Selected genetic resources have been evaluated for growth attributes through progeny testing. After three years of planting, the survival percentage of 20 CPTs from 65% to 95%, indicating that this assemblage is performing well. Notably, a single tree CPT 20 (Chitteri) has exhibited exceptional growth characteristics, recorded at a height of 9.50 m and a girth of 58 cm. Once the trees achieve desirable growth, quality seeds will be collected and it will recommended for elite clone production.



Terminalia chebula


The objective of this experiment is to form a seedling seed orchard for gallnut to produce genetically superior seeds. A total of 1,200 plants were selected from five CPTs from various locations in Tamil Nadu. The research trial spans 3 hectares, with a spacing of 5 m x 5 m and a pit size of 80 cm³. Among these, 674 plants have survived after 16 years. Notably, CPT No. 5 (Javadu Hills-2) has been identified as the best-performing progeny based on mean morphometric and seed characteristics. It shows superior growth parameters and produces high-quality seeds compared to the other CPTs. This plot effectively serves the purpose of seed collection and is recommended for use as a seed orchard.


Seaweed or Macroalgae refers to thousands of macroscopic, multicellular, marine algal species which provide essential nursery habitat for fisheries and other marine species. The present study aims to develop economically feasible new alternative cultivation techniques of native seaweeds such as 1. Gellidia acerosa, 2. Hypnea valentia, 3. Padina gymnospora, 4. Ulva lactula and 5. Gracilaria salicornia in the Mandapam coast areas. More importantly, this study would help to replace the cultivation of invasive exotic seaweed (Kappaphycus spp.) the primary source for macroalgae aquaculture in the Gulf of Mannar. Two cultivation methods namely, Raft and Cage methods are used in this study; all five species grow well in both methods. Among the five species Hypnea valentia and Padina gymnospora gave better yield compared to other species. Results from this study will be beneficial for local fisherman and farmer community in coastal areas.








Afforestation in problem sites is a complex but rewarding endeavor that may provide ecological and economic benefits and requires careful planning, execution and management. This experiment was established from 125 number of seedlings with six species namely, 1. Ficus benghalensis, 2. Ficus religiosa, 3. Ficus retusa, 4. Annona squamosa, 5. Gyrocarpus americanus and 6. Sterculia foetida were planted at Perumalmalai Research Centre of Melur Research Range, AFRD, Madurai. At present 71 plants were survived. After reviewing of findings and observation the penetration of the roots of Ficus benghalensis and Sterculia foetida into the crevices of the rocks has been identified.
Gyrocarpus americanus and Ficus benghalensis species were found to be suitable for afforestation in problem sites.
“When the rrots are deep, there is no reason to fear the wind.”
Tmt. P. Banupriya, ACF, AFRD
Designing a model shelter belt to arrest whirlwind velocity and shifting of sand dune in Poochikadu Theri R.F through Tirunelveli Research Range. This experiment was established in an area of 3.75 ha with six species (Eucalyptus tereticornis; Albizia lebbeck; Azadirachta indica; Derris indica; Casuarina junghuniana; Agave spp.) in three different models namely, Model 1: Strip line planting; Model 2: Staggered method and Model 3: Criss-cross method (opposition direction of the wind). Based on the study it can be concluded that, Model Wise: wind speed significantly reduced from Model 1 and model 2 (10.4 Km/hr to 5.6 Km/hr). Eucalyptus tereticornis and Albizia lebbeck are found to be suitable for planting in Theri Soil to arrest wind velocity. A well-planned shelter belt can significantly reduce wind speed and protect the surrounding area from whirlwinds.




Farmers were given awareness regarding cultivation of agroforestry crops and various agroforestry models. Trees which can be used as wind barrier around banana and horticulture plantation was suggested to farmers. Queries of farmers related to various Timber yielding trees, Silvicultural practices, their market demand and market linkage were addressed. Cultivation methods of Decalepis hamiltonii (Maahali Kizhangu) was demonstrated. Medicinal uses and market value of D. hamiltonii was explained to the farmers.
During 2019-2020 under TBGP Scheme, the Introduction Trial of Terminalia chebula had been laid in three research Centre of industrial wood research division. This experiment was established from seed Origin and Sprigs Origin All planted seedlings are growing well and established. In all three research Centre (Arimalam, Managathi and Ammayapuram) Survival wise seed origin performs well.


Assembling the planting material and assembling CPT’s planting materials
During 2023-24 under TBGPCCR scheme Assembling the planting material and assembling CPT’s planting materials experiment were laidin Arimalam Research center in Pudukottai Research Range Among the planted 10CPTs, CPT-1 (Tree. No 37 - Gopalasamudram Research Centre) CPT-7 (Tree. No 189-Gopalasamudram Research Centre) CPT- 9 (Tree. No 303 - Gopalasamudram Research Centre) performs well in height wise.


During 2019-2020 under JA Research schemeTerminalia paniculatawill be plantedastrial in plains regions of different zone. Likely, Southern zone of Arimalam Research Centre in Pudukkottai Research Range Cauvery delta zone of Ammayapuram Research Centre in Trichy Research Range Cauvery delta zone of ManagathiResearchcentre in Jeyankondam Research Range.This experiment was established from seed Originand Sprigs Origin All planted seedlings are growing well and established. All the three research Centre (Arimalam, Managathi and Ammayapuram) Survival wise seed origin performs well.


During 2005-2006 Assemblage of 20 economically important tree species out of 20 species Crescantia cujete was the only species to start flowering likely due to a combination of its unique biological traits and environmental condition. This species may have specific flowering requirments such as reaching a particular age or level of resource accumulation that allowed it to flowering and additional environmental factors. The tree's large, hard-shelled fruit is often dried and transformed into bowls, musical instruments, and decorative items, playing an important role in traditional crafts







The training on Research Activity, Nursery Techniques and Medicinal Plants for 150 Students at wisdom Wealth international School is designed to introduce students and teachers to the basics of plant cultivation and the importance of medicinal plants. The program aim to spark interest in sustainable practice and environmental care, encouraging students to apply these skills in their future careers..


“There's


Biofertilizers are suspensions having agriculturally useful microorganisms such as Rhizobium, Azospirillum, Pseudomonas, Bacillus and Azotobacter, which fix atmospheric nitrogen, solubilize insoluble phosphates, and make them available for plants. This Biofertilizer is environmentally friendly, gives uniform results for most crops (Blending 25% Fish Amino acid + 75% liquid biofertilizer was found to have the best efficiency) and directly reduces the use of chemical fertilizer by 15 to 40%. The shelf life of the liquid biofertilizer is higher (in the range of one to two years) compared to that of solid matrix base biofertilizer. There is a growing demand for organic foods in the global market. The use of these liquid biofertilizers would help farmers to produce organic crops to compete in the global market.

The traditional method requires more than one year to convert the dead branches and other woody parts into compost. Using modern techniques, the time required is considerably reduced, and composting the entire biomass without any wastage is achieved. By using the Shredder, Pulverizer machinery the dead branches and twigs are converted into small fragments. Large quantities of Biowaste are tackled with the use of these machineries. The time required is considerably reduced and composting the entire biomass without any wastage is achieved. Indirect benefit of minimizing fire hazard in the wood lots.




Huge quantity of Biowaste generated in the Forestry and Agricultural sector is converted into Biofertilizer and ultimately used in these sectors.
Plastics are man-made long chain polymeric molecules. They are very stable and not readily degraded in the ambient environment. Therefore to save capacity for plastic waste disposal, a worldwide research effort to develop biodegradable polymers as a waste management option for polymers in the environment. Biodegradation (i.e. Biotic degradation) is a chemical degradation of materials (i.e. Polymers) provoked by the action of microorganisms such as bacteria and fungi.
Soil samples have been collected from different sizes and different tree species of Bio-composite plastic bags (10x20, 13x25 & 16x30 cm) at Melur (R) Range, Madurai (R) Division for the isolation and identification of the plastic degrading bacterial strains.

The bacterial strains are identified from the seven selected strains.


Mannitol-Motility test



In this study, microbial counts in the degrading materials were recorded up to 0.0278x10 per gram for total heterotrophic bacteria. The microbial species found associated with the degrading materials were identified as two Gram positive and five Gram negative bacteria. From the observations it is confirmed that a strain of bacterial species associated with the polythene materials were identified as Bacillus and Pseudomonas (due to the green colour).
Dr. K. Arivoli, DCF, SFRI
Dr. S. Aghizion Inbakani
Project Associate
“No
research without action, no action without research”
I must sound like a broken record. Even though our native plantings are only a few years old, I see more insects/birds each year and a greater diversity of insect/bird species. I saw so many butterflies, including ones I had never seen before.
There were multiple butterflies in our Forest Genetic Resources Tree Park almost every day. They were around so often, but I couldn’t stopped running outside with the camera every time someone shouted ‘BUTTERFLY!’ At times, I felt like a Disney prince with butterflies fluttering around me as I worked outside. In the future, I may have to start planting favorable plants to our unexpected guests - Butterflies...










Butterflies are excellent educational tools and trigger interest in conservation. Most people are more interested in learning about and protecting butterflies than less attractive species. By protecting butterflies, we can indirectly protect many other species and ecosystems as a whole. Being in nature is great for mental health, and most people particularly enjoy seeing beautiful butterflies in their gardens.
“EK PED MAA KE NAAM”- A TREE AS TRIBUTE TO MY MOTHER
It’s that time of year again: tree planting season! Our Hon’ble Prime d h

“Trees








“If we lose the forests, we lose our only teachers.”
A group of 52 students along with teachers from Department of Pharmacy, Madras Medical College, Chennai visited Medicinal plants garden, nursery and Forest Genetic Resources Tree Park at State Forest Research Institute Kolapakkam on August 2024. They were briefed about the research and development activities of the institutes.





“Do






“Nature does not hurry, yet everything is accomplished ”


Quality seeds, sourced from our established SSO/CSO/SPA/Seed Stand or CPT, may be procured from M R Palayam Seed Centre, Trichy under Modern Nursery Division.
STOCK (AS ON 30/09/2024):


Phosphobacteria & Azospirillum are produced and stocked at our Laboratory in Dharmapuri
Pseudomonas fluorescens, Trichoderma viride, Rhizobium and Frankia can be supplied on demand
VAM and Vermicasting are produced at various Research Centres of MND Division

Dharmapuri, Thoppur, Harur, Valkaradu, Kalamaoor, Alwarmalai

Please Note: Payment for Seeds / Bio-fertilizers may be made through



Dr. Thiru. K. Arivoli, DCF SFRI Division, Chennai dcfsfri@gmailcom, +91 (44) 22750297
Dr. Thiru. R. Rajmohan, DCF
Forest Genetics Division, Coimbatore. cfgeneticscbe@yahoo.in, +91 (422) 2434791.
Thiru. T. Kannan, DCF Modern Nursery Division, Dharmapuri. dmudpimn@gmail.com, +91 (434) 2296385.
Thiru. K. Saravanakumar, DCF
Industrial Wood Research Division, Trichy. dcfiwrdmukkombu@gmailcom, +91 (431) 2614723
Tmt. P. Banupriya, ACF Agro Forestry Research Division, Madurai afrmdu@gmailcom, +91 (452) 2531148
Editor
Thiru. Nihar Ranjan, IFS
Chief Conservator of Forests (Research) SFRI Campus, Kolapakkam, Chennai - 600127. ccfresearchchennai@gmail.com, +91 (44) 22751250.